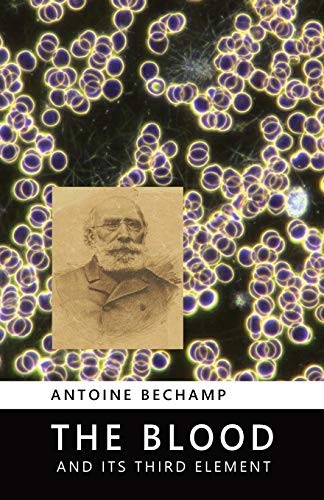
The Blood and Its Third Element

The Blood and Its Third Element
(Autor) Antoine Bechamp
Formato:
Paperback
£13,95
Precio: £13,53
(3% off)
In Stock
(Limited availability – contact us to confirm)
Generally dispatched in 1 to 2 days
Information
Editorial:
Metropolis Ink
Formato:
Paperback
Idioma:
en
ISBN:
9780957985872
Año de publicación:
2002
Fecha publicación:
11 de Septiembre de 2002